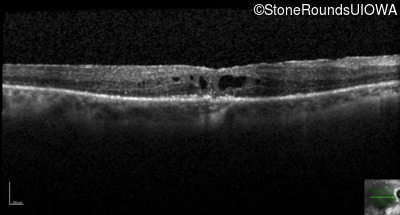
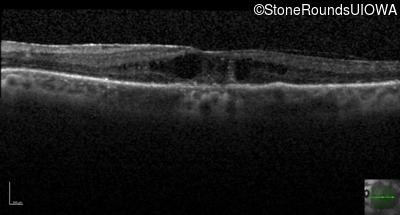
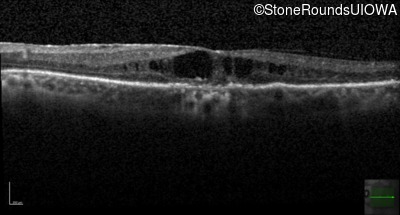
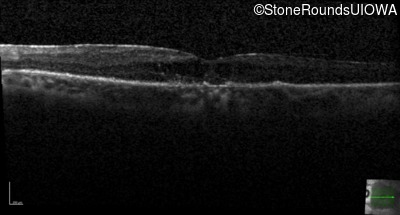
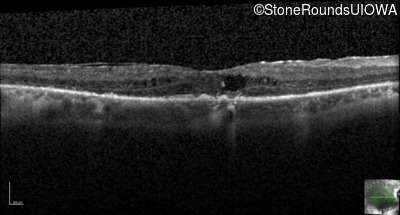
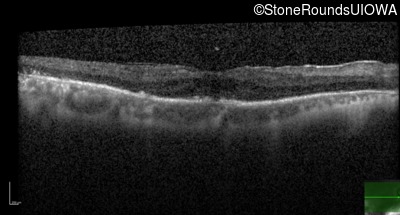
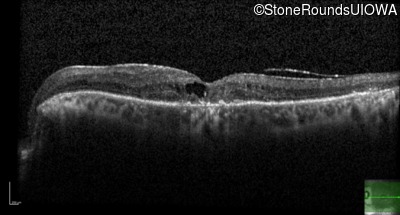
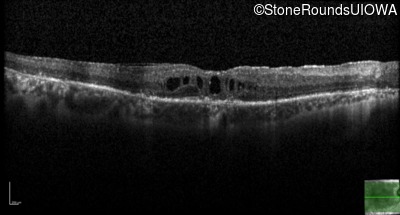
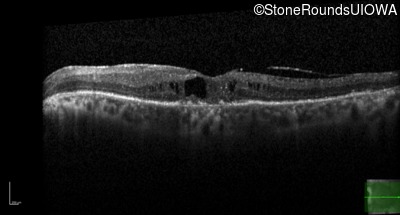
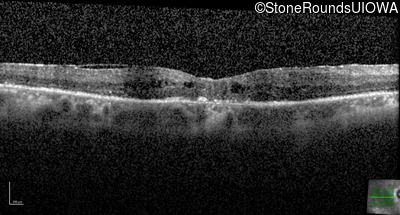
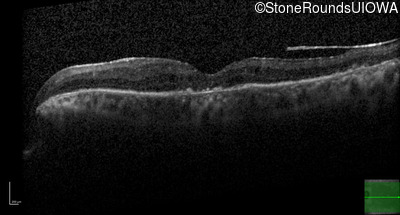

Case
SR130
Student Mode
AR Retinitis Pigmentosa (IA1aiii)
Male
Male
Hidden
SR130
Student Mode
AR Retinitis Pigmentosa (IA1aiii)
Male
Male
| Age at visit: 65 years |
| Age at visit: 66 years |
| Age at visit: 67 years |
| Age at visit: 68 years |
| Age at visit: 69 years |
| Age at visit: 70 years |
Diagnosis & molecular findings
| Disease | Gene | Allele 1 variant(s) | Allele 2 variant(s) | Inheritance mode |
|---|---|---|---|---|
| AR Retinitis Pigmentosa | IFT172 | Ala644Glu GCG>GAG | Arg1284Stop CGA>TGA | AR |
Disease:
Gene:
Allele 1:
Ala644Glu GCG>GAG
Allele 2:
Arg1284Stop CGA>TGA
Inheritance:
AR